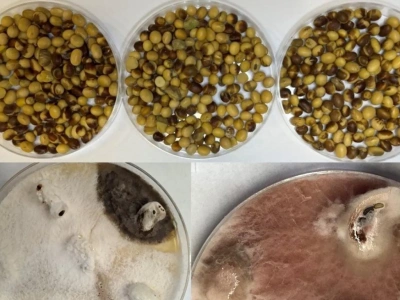
Groźne grzyby mogą być ukryte w nasionach soi! Osłabione wschody i plonowanie

Soja przez lata uchodziła za uprawę stosunkowo bezpieczną pod względem chorób. Jednak ostatnie sezony pokazują, że sytuacja zaczyna się zmieniać, a problem może pojawiać się już na etapie siewu. Coraz częściej w materiale siewnym wykrywa się patogeny, które mogą osłabiać wschody i wpływać na plonowa...
źródło: https://www.topagrar.pl/articles/straczkowe/grozne-grzyby-moga-byc-ukryte-w-nasionach-soi-oslabione-wschody-i-plonowanie-2638873
dodano: 07-02-2026 20:07:09
Inne znaleziska:
Grzyby 2025 koło Wrocławia. Gdzie na grzyby? Dobre miejsca na grzyby na Dolnym Śląsku [LISTA MIEJSC...
Grzyby 2025 koło Wrocławia. Gdzie na grzyby? Dobre miejsca na grzyby na Dolnym Śląsku [LISTA MIEJSC 2025]
Gdzie na grzyby koło Wrocławia? Przedstawiamy Wam kilka ciekawych miejsc na Dolnym Śląsku, gdzie warto pójść na grzyby. Co ważne grzybobranie można urządzić sobie nawet nawet nie tyle, co w bezpośrednim sąsiedztwie Wrocławia, ale nawet w granicach mi...
wroclife.pl
15-09-2025 09:03:09
15-09-2025 09:03:09
Grzyby 2025. Gdzie na grzyby koło Wrocławia. Grzybobranie na Dolnym Śląsku
Grzyby 2025. Gdzie na grzyby koło Wrocławia. Grzybobranie na Dolnym Śląsku
Gdzie na grzyby koło Wrocławia? Przedstawiamy Wam kilka ciekawych miejsc na Dolnym Śląsku, gdzie warto pójść na grzyby. Co ważne grzybobranie można urządzić sobie nawet nawet nie tyle, co w bezpośrednim sąsiedztwie Wrocławia, ale nawet w granicach mi...
wroclife.pl
05-11-2025 09:37:10
05-11-2025 09:37:10
Uwaga! Zabawki Labubu mogą być groźne dla dzieci. Austriackie władze alarmują
Uwaga! Zabawki Labubu mogą być groźne dla dzieci. Austriackie władze alarmują
Popularne maskotki z serii Labubu mogą być niebezpieczne dla najmłodszych. Takie ostrzeżenie wydała austriacka Agencja ds. Zdrowia i Bezpieczeństwa.
wpolsce24.tv
17-10-2025 18:08:09
17-10-2025 18:08:09
Młodzi Polacy łykają je na potęgę. Mogą być groźne dla zdrowia
Młodzi Polacy łykają je na potęgę. Mogą być groźne dla zdrowia
Badania przeprowadzone przez naukowców z Kanady wskazują na potencjalne skutki niedoboru snu wynikające ze stosowania suplementów przedtreningowych. Tymczasem w Polsce "przedtreningówki" i inne suplementy diety z roku na rok bierze coraz więcej osób.
finanse.wp.pl
11-03-2026 08:57:06
11-03-2026 08:57:06
Kupujesz grzyby? Na to musisz zwracać uwagę. Błędy sprzedawcy mogą odbić się na twoim zdrowiu
Kupujesz grzyby? Na to musisz zwracać uwagę. Błędy sprzedawcy mogą odbić się na twoim zdrowiu
Sezon na grzyby to gratka nie tylko dla grzybiarzy, ale też smakoszy. Czas ten niesie jednak ze sobą również pewne zagrożenia. Jednym z nich jest pomylenie grzybów jadalnych z trującymi, ale to nie wszystko. Okazuje się, że zaszkodzić może nam właści...
g.pl
02-09-2025 14:12:13
02-09-2025 14:12:13
Poszedł na grzyby, a dokonał niesamowitego odkrycia. Tu mogło być cmentarzysko
Poszedł na grzyby, a dokonał niesamowitego odkrycia. Tu mogło być cmentarzysko
W lesie nieopodal Olecka w trakcie grzybobrania członek stowarzyszenia historycznego Archeo natrafił na niezwykłe znalezisko. Na niewielkim wzniesieniu, w pobliżu wsi Gryzy, odkrył pierścień, dwa dzwoneczki oraz inne artefakty, które według wstępnych...
fakt.pl
16-10-2025 23:08:05
16-10-2025 23:08:05
Shadow AI - ukryte zagrożenie. Dlaczego niekontrolowane narzędzia mogą kosztować miliony?
Shadow AI - ukryte zagrożenie. Dlaczego niekontrolowane narzędzia mogą kosztować miliony?
Shadow AI – czyli korzystanie z nieautoryzowanych narzędzi sztucznej inteligencji – to rosnące zagrożenie dla firm, które może prowadzić...
egospodarka.pl
17-02-2026 15:01:08
17-02-2026 15:01:08
Wielka płyta kusi niską ceną. Te ukryte pułapki mogą wywindować koszty w kosmos
Wielka płyta kusi niską ceną. Te ukryte pułapki mogą wywindować koszty w kosmos
Niższa cena mieszkań w blokach z wielkiej płyty potrafi działać jak magnes — ale właśnie wtedy warto włączyć najwyższą czujność. Zakup takiego lokalu bywa bardziej wymagający niż w przypadku nowej inwestycji, bo za atrakcyjną ofertą mogą kryć się rze...
kb.pl
12-04-2026 22:56:49
12-04-2026 22:56:49
Ukryte zagrożenie w jedzeniu. Te pleśnie mogą prowadzić do raka wątroby
Ukryte zagrożenie w jedzeniu. Te pleśnie mogą prowadzić do raka wątroby
Aflatoksyny obecne w żywności mogą znacząco zwiększać ryzyko raka wątroby. Naukowcy alarmują, że w połączeniu z otyłością, cukrzycą i niewłaściwą dietą tworzą wyjątkowo niebezpieczny miks.
farmer.pl
26-04-2026 18:45:28
26-04-2026 18:45:28
Przez 5000 lat zielone kamienie były ukryte w jaskini wysoko w górach. Teraz mogą zmienić historię
Przez 5000 lat zielone kamienie były ukryte w jaskini wysoko w górach. Teraz mogą zmienić historię
Górskie jaskinie potrafią skrywać wiele tajemnic, o czym przekonali się jakiś czas temu archeolodzy w hiszpańskiej części Pirenejów. W jednej z nich udało im się odnaleźć ślady świadczące o pobytach prehistorycznych ludów na znacznych wysokościach, c...
android.com.pl
18-05-2026 10:17:10
18-05-2026 10:17:10
![Grzyby 2025 koło Wrocławia. Gdzie na grzyby? Dobre miejsca na grzyby na Dolnym Śląsku [LISTA MIEJSC 2025] 81 Grzyby 2025 koło Wrocławia. Gdzie na grzyby? Dobre miejsca na grzyby na Dolnym Śląsku [LISTA MIEJSC 2025]]( https://www.znalezisko.pl/storage/z_thumb/68c7ba2d592be.jpg)








